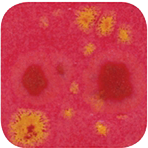

Amaco
Amaco Crystaltex Glaze CTL52 Watsonia
Amaco Crystaltex Glaze CTL52 Watsonia
Couldn't load pickup availability
Multi-color effects can be subtle as with #32, which fires to a creamy yellow peppered with rich brown, or they can be flashy like the red, white and blue of #54.  No two pieces will ever be alike, but all will be unique.  
These liquid glazes consist of a basic color with the addition of one or more crystals of contrasting colors.  
For application by dipping or pouring, thorough stirring of the glaze is necessary since the crystals settle to the bottom of the jar.  
A more controlled decorative effect is obtained by brushing; the brush is dipped in glaze at the top of the jar and two or more coats applied.  Then the crystals which will have settled to the bottom are lifted with the brush and placed where desired.  Crystals fan out on flat horizontal surfaces and run on vertical pieces.
All are lead free. All are AP Non-Toxic except for #20 and #26. All are dinnerware safe except #30, 32, 43, 52, and 69.
Apply to cone 04 mature bisque and fire at cone 05
Materials
Materials
Shipping & Returns
Shipping & Returns
Dimensions
Dimensions
Care Instructions
Care Instructions